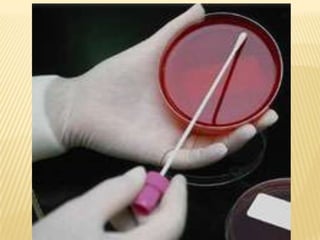
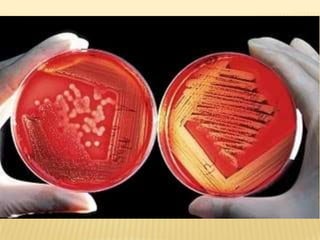
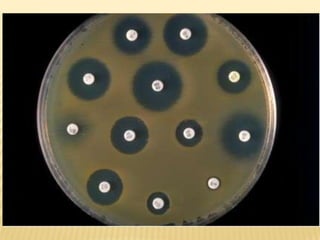

This document discusses acute respiratory failure and its causes, presentation, diagnosis, and treatment. It begins by differentiating pediatric and adult airway anatomy. Acute respiratory failure is then defined as the failure of gas exchange in the lungs. Causes can be extrapulmonary, such as brain or spinal cord issues, or intrapulmonary like infections or blood clots in the lungs. Assessment involves blood tests and imaging to identify the underlying problem. Treatment aims to support breathing and oxygenation through positioning, ventilation support, medications, and treating any underlying issues. Nursing priorities are optimizing gas exchange and managing complications.